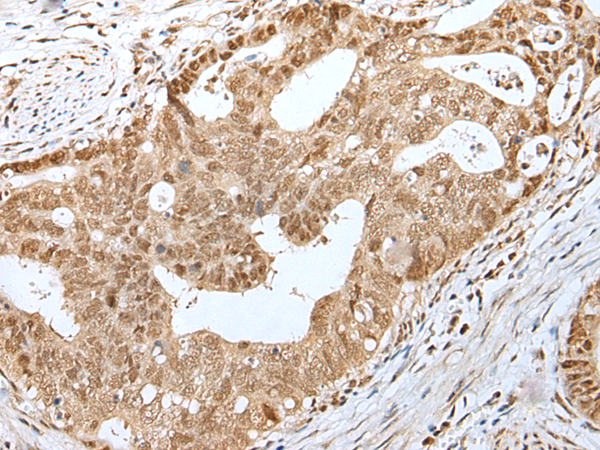

中文名稱:兔抗BIRC7多克隆抗體
|
Background: |
This gene encodes a member of the inhibitor of apoptosis protein (IAP) family, and contains a single copy of a baculovirus IAP repeat (BIR) as well as a RING-type zinc finger domain. The BIR domain is essential for inhibitory activity and interacts with caspases, while the RING finger domain sometimes enhances antiapoptotic activity but does not inhibit apoptosis alone. Elevated levels of the encoded protein may be associated with cancer progression and play a role in chemotherapy sensitivity. Alternative splicing results in multiple transcript variants |
|
Applications: |
ELISA, IHC |
|
Name of antibody: |
BIRC7 |
|
Immunogen: |
Synthetic peptide of human BIRC7 |
|
Full name: |
baculoviral IAP repeat containing 7 |
|
Synonyms: |
KIAP; LIVIN; MLIAP; RNF50; ML-IAP |
|
SwissProt: |
Q96CA5 |
|
ELISA Recommended dilution: |
2000-5000 |
|
IHC positive control: |
Human gastric cancer and human tonsil |
|
IHC Recommend dilution: |
25-100 |

購物車
幫助
021-54845833/15800441009
